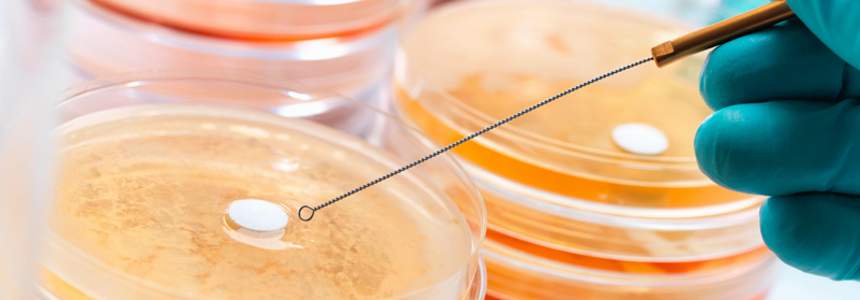

發布人:中營質檢 發布時間:2021-07-24
食品微生物檢測
服務內容
1、食品微生物檢測,協助企業了解食品安全
2、食品微生物污染分析,協助企業分析產品污染源
3、食品微生物菌種鑒定,協助企業分離優勢菌種
檢測范圍
常見食品微生物檢測類別:奶制品、罐頭食品、調味品、蛋制品、淀粉類制品、發酵非發酵性豆制品、谷物類、冷冰飲品、糖果以及飲用天然礦泉水等。
檢測項目
| 類別 | 項目名稱 |
| 非致病菌 | 菌落總數、大腸菌群、糞大腸菌群、大腸桿菌、霉菌、酵母菌、乳酸菌。 |
| 致病菌 | 沙門氏菌、單核增生李斯特氏菌、志賀氏菌、金黃色葡萄球菌、副溶血性弧菌、霍亂弧菌、綠膿桿菌、溶血性鏈球菌、產氣莢膜梭菌、蠟樣芽孢桿菌、大腸埃希氏O157:H7、致瀉大腸埃希氏菌等。 |
| 其他 | 罐頭食品的商業無菌、厭氧菌落總數、厭氧亞硫酸鹽還原菌、 |
| 需氧嗜溫菌芽孢、厭氧嗜溫菌芽孢、嗜熱嗜酸菌、嗜熱菌落總數等。 |
中營質檢為正規的第三方檢測機構,檢測范圍:食品檢測、保健品檢測、水及涉水產品檢測、化妝品檢測、消殺產檢測等,檢測儀器齊全、檢測團隊檢測經驗豐富,全國多家分支檢測室,支持上門取樣或寄樣檢測服務,檢測報告支持掃碼查詢真偽。
上一篇:獸藥殘留檢測機構
下一篇:食品毒害物質檢測機構